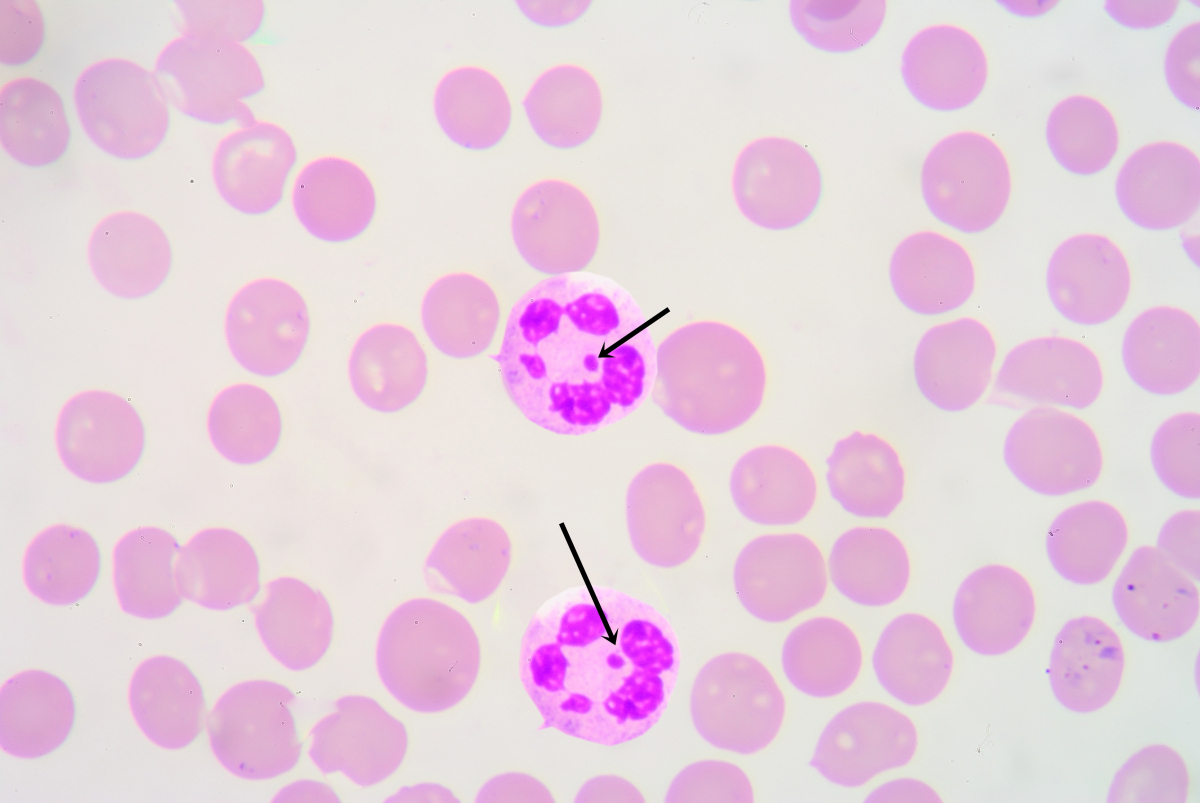

支原体妇科病是指由支原体感染引发的妇科疾病具体而言病原体特征支原体是一类无细胞壁的原核微生物,体积微小,形态多样与妇科疾病关联密切的主要是解脲支原体和人型支原体这类微生物对环境抵抗力较弱,但可通过特定途径在人体间传播传播途径主要通过性接触传播,是支原体感染的主要方式此外,间接;支原体是一类没有细胞壁介于病毒与细菌之间的最小原核细胞型微生物其核心特征与分类如下1 结构与形态特征支原体属于原核生物,但缺乏细菌典型的细胞壁结构,这使其对青霉素等干扰细胞壁合成的抗生素天然耐药其形态具有多形性,可呈现球形丝状或分支状等不同形态,直径通常在0203微米之间。
支原体感染是一种由支原体引起的传染病其症状和表现因感染部位和个体差异存在不同,常见感染类型如下一呼吸道感染以支原体肺炎最为典型,主要表现为持续性咳嗽咳痰痰液多为白色黏液发热多为低热或中度发热胸痛部分患者可能伴随头痛乏力等全身症状此外,支原体感染还可引发咽炎;支原体感染是由支原体这种微生物引发的感染性疾病一支原体类型与感染部位支原体是一类缺乏细胞壁的原核微生物,其种类多样,常见的致病性支原体包括肺炎支原体生殖道支原体等肺炎支原体主要侵犯呼吸道,可引发上呼吸道或下呼吸道疾病生殖道支原体则可能感染泌尿生殖系统,导致相关炎症二疾病特点与危害。
衣原体和支原体均属于病原微生物,是引发感染性疾病的常见病原体衣原体是一类严格真核细胞内寄生具有独特发育周期的原核细胞型微生物它不能独立进行代谢活动,必须依赖宿主细胞提供能量和营养衣原体感染人体后,可引发多种疾病,如肺炎衣原体感染主要累及肺部,导致肺炎衣原体肺炎,患者常出现发热咳嗽。
1呼吸道症状支原体感染最常见的症状是呼吸道症状,包括咳嗽咳痰胸闷气喘等这些症状可能会持续数周甚至数月,严重影响患者的日常生活 2发热支原体感染还可能引起发热,患者可能会出现体温升高畏寒乏力等症状 3肌肉疼痛支原体感染还可能引起肌肉疼痛,特别是对于那些经常进行体育锻炼或体力劳动的人来说,这种症状;支原体感染是由支原体这种微生物引发的感染性疾病支原体是一类特殊的微生物,它缺乏细胞壁,属于原核细胞型微生物,大小一般在03 05um之间,形态多样,有球形杆形丝状分枝状等支原体既不同于细菌,也不同于病毒,具有种类繁多分布广泛的特点,在人体动物植物及昆虫等多个领域都。
支原体感染是一种由多种致病性支原体引起的感染性疾病病原体特性支原体是一类缺乏细胞壁的原核细胞型微生物,其大小介于细菌和病毒之间,广泛分布于自然界人类常见的致病性支原体包括肺炎支原体人型支原体生殖支原体和解脲脲原体等感染症状症状因感染部位不同而有所差异肺炎支原体主要引起呼吸道;支原体是一类缺乏细胞壁呈高度多形性能通过滤菌器在无生命培养基中能生长繁殖的最小原核细胞型微生物生物学特性支原体没有细胞壁结构,形态高度多变,可通过滤菌器孔径022045微米,是已知能独立生存的最小原核生物其基因组较小约058138兆碱基对,代谢能力有限,需。
支原体感染是由支原体这种微生物引发的感染性疾病,严重程度需结合具体感染部位判断,多数情况下规范治疗后可彻底治愈,总体不属于严重疾病感染类型与症状支原体感染根据感染部位不同,临床表现各异若感染泌尿生殖系统如尿道,可能引发非淋菌性尿道炎,表现为尿道刺痒排尿疼痛分泌物增多若感染呼吸;支原体是一类介于病毒和细菌之间的原核微生物,其核心特征为缺乏细胞壁结构,属于柔膜体纲Mollicutes这类微生物的基因组较小,代谢能力有限,需依赖宿主提供部分营养物质,因此具有独特的生物学特性分类与多样性自然界中已发现约100种支原体,其中与人类健康密切相关的主要是肺炎支原体和解脲支原体前。
支原体感染是指由支原体这一病原体引发的感染性疾病支原体是一类特殊的微生物,其分子量介于细菌与病毒之间与细菌相比,支原体的细胞结构更为简单,缺乏细胞壁这一典型结构与病毒相比,支原体具有独立的代谢能力,可在无生命培养基中生长繁殖这种独特的生物学特性使其成为介于细菌与病毒之间的第三类微;支原体是一类特殊的病原体,属于微生物范畴其核心特征如下1 结构特点支原体是已知唯一无细胞壁的原核生物,这一特性使其形态多样球状丝状等,且对青霉素等破坏细胞壁的抗生素天然耐药其体积介于细菌约110微米和病毒约20300纳米之间,直径通常为0203微米,需通过电子显微镜。
支原体是一种病原微生物,属于原核生物界中最小的一类微生物,其大小介于细菌与病毒之间它没有细胞壁结构,这一特性使其对许多针对细胞壁合成的抗生素如青霉素类天然耐药,但可通过干扰蛋白质合成或DNA复制的抗生素进行治疗支原体感染以泌尿生殖道为主,常见疾病为尿道炎患者典型症状包括尿道刺痒;支原体感染是一种常见的妇科感染性疾病,是由人型支原体生殖支原体或解脲支原体感染人体所导致的如果严重的说,也属于性传播疾病之一,这种疾病的主要发病原因就是不洁性生活年轻女性是这种疾病的高发人群,如果平时不注意个人卫生,也很容易导致支原体感染如果耽误了最佳的治疗时机,不但会导致疾病症状。
支原体是一类没有细胞壁形态多样的病原体,广泛存在于人体及动物体内病原学特性支原体属于原核生物界,其细胞结构缺乏细胞壁,这一特征使其形态具有高度可变性,可呈现球形丝状或分支状等不同形态由于无细胞壁结构,支原体对作用于细胞壁合成的抗生素如青霉素类天然耐药,但对干扰蛋白质合成。

京公网安备11000000000001号
京公网安备11000000000001号 京ICP备11000001号
京ICP备11000001号
还没有评论,来说两句吧...